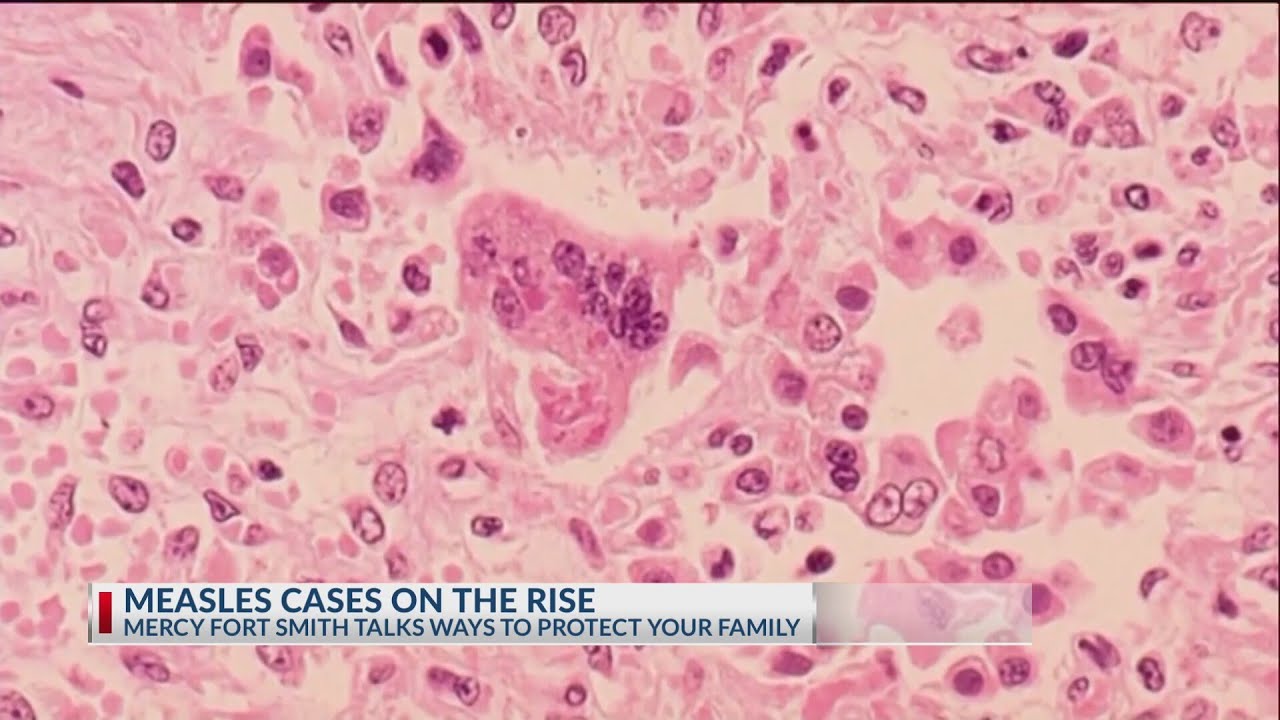

Fort Smith Ar Escorts
Twink Jerk
Submit My Milf
Sonic Project X Love Disaster
Rose Desperate Amateurs Full
Jacqueline Arroyo Nude
Black Nasty Anal
Brunette sucking cock photos
Dominicana higuey rosanna amiga
Shaved Pussy Chanel Bryant Fucks And Sucks A Hard Cock For The First Time
Coco Kiss Anal Video
Bisexual videos free movies
Hanging Pussy Lips Fuck
Sweet Vicky Nude
Fort Smith Ar Escorts 116 photos